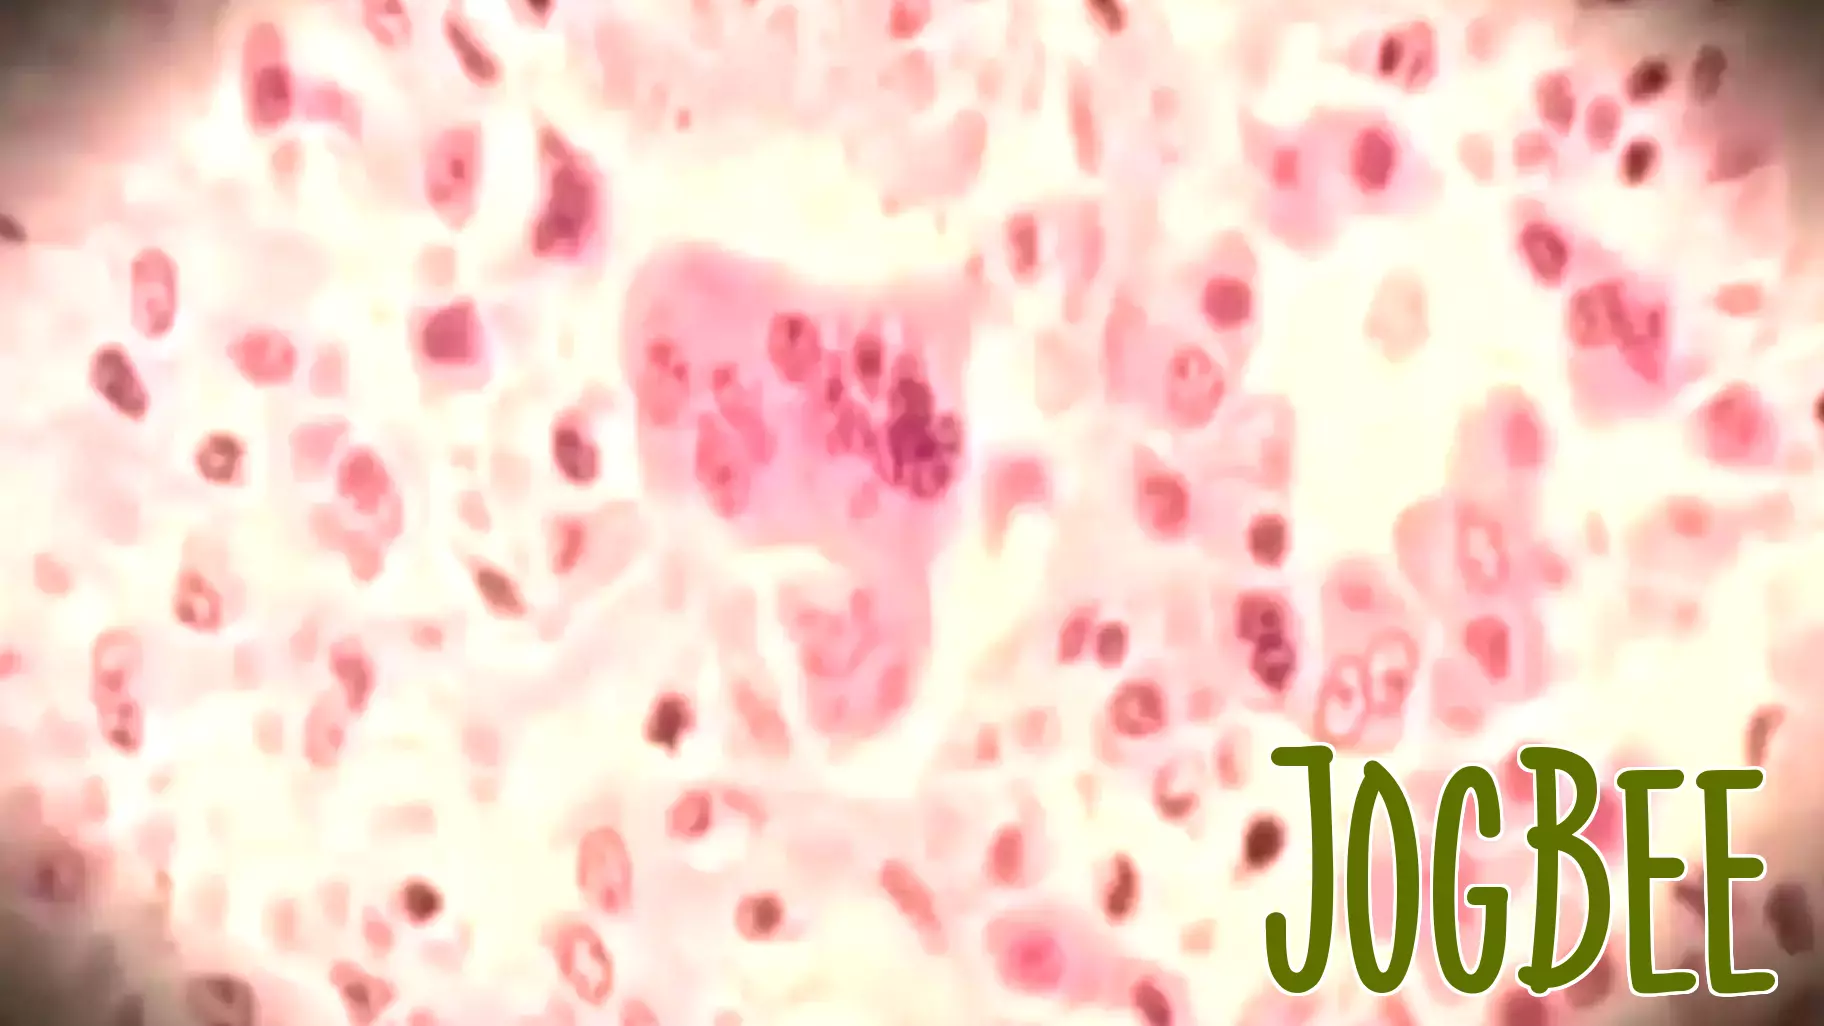
Potential Measles Exposure at Newark Airport

December 28, 2025 - 15:54
New Jersey's Health Department has issued a warning regarding a possible measles exposure at Newark Airport. Officials reported that an individual infected with the highly contagious virus passed through the airport on Friday, December 19. This incident has raised concerns among travelers and airport staff, as measles can spread rapidly in crowded environments.
Health authorities are urging anyone who was at Newark Airport on that date to monitor themselves for symptoms of measles, which can include high fever, cough, runny nose, and a distinctive rash. Symptoms typically appear 7 to 14 days after exposure, making it crucial for individuals to remain vigilant during this period.
The Health Department is working to identify and contact those who may have been directly exposed. Vaccination remains the most effective way to prevent measles, and health officials encourage those who are not vaccinated or unsure of their vaccination status to seek immunization. The situation is being closely monitored to ensure public safety and health.
May 25, 2026 - 17:15
Exploring Travel Sports: Highs and LowsTravel sports have become a major part of childhood for many families, with weekend tournaments and long drives to games becoming the norm. But beneath the surface of competition and college...
May 25, 2026 - 07:17
Workplace partners: Rogue Valley medical team targets employee health and recoveryA southern Oregon medical group is working to keep local workers healthy and back on the job faster after an injury. Valley Immediate Care has built a program around occupational health and injured...
May 24, 2026 - 21:17
Fruit-Flavored Vapes Grow More Accessible, Raising New Safety QuestionsRecent decisions by the U.S. Food and Drug Administration have quietly reversed a years-long crackdown on fruit-flavored e-cigarette pods, making these products more available on store shelves. The...
May 24, 2026 - 08:43
Home 'sick' home? Here’s how to keep your house healthyMichael Reed entered first, turning on the lights to make it feel like home before the clients arrived. He flipped switches as he walked through the formal living room, the kitchen, and the hallway...